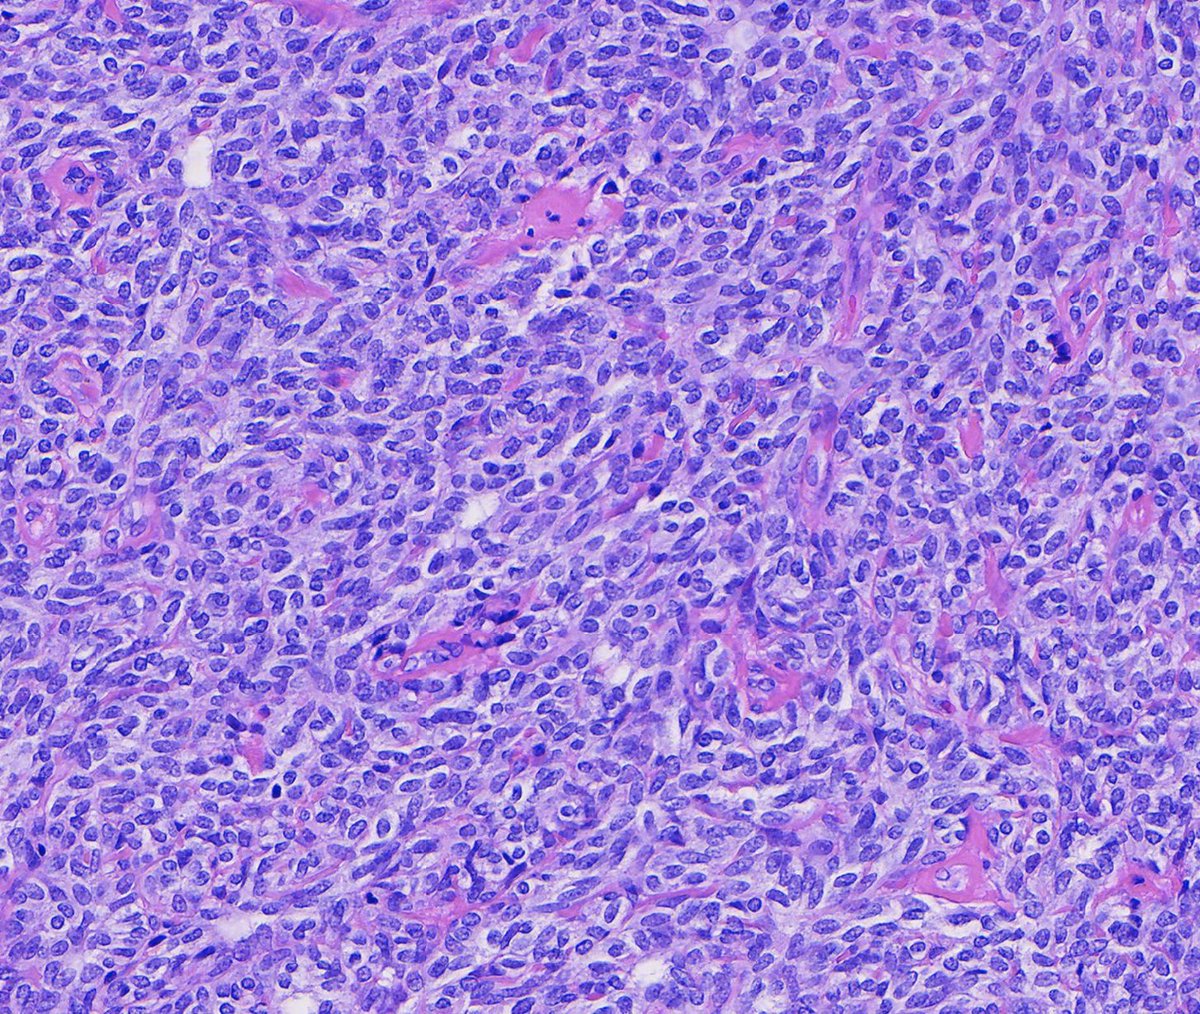
Toby Schmitt, MD tweet media

Sabitlenmiş Tweet

Couldn't be more excited to announce the launch of pathlibrary.com, the virtual slide site I wish had existed during my pathology residency. You can:
- Order special stains to work up cases
- See annotated histologic features
- Prepare for exams with board-style questions

English